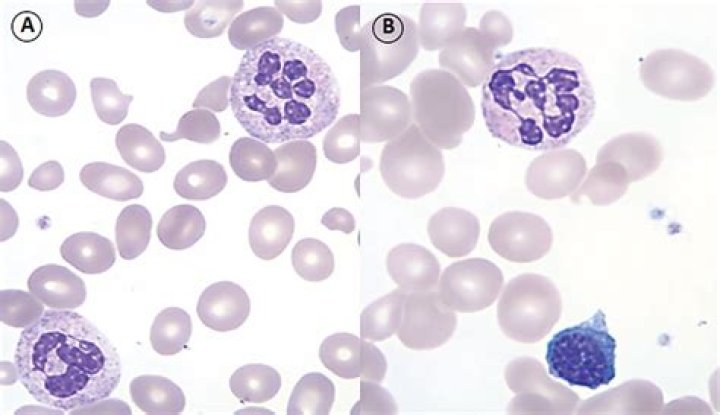

Answer: Only male turkeys, or toms, can gobble, and they mostly do it in the spring and fall. It is a mating call and attracts the hens. Wild turkeys gobble at loud sounds and when they settle in for the night.
Do turkeys actually gobble?
Only males gobble
There's a reason that male turkeys are called "gobblers" — they're the only ones that make that noise! Each gobbler has a unique call that he uses to attract females during breeding season. Female turkeys also make distinct noises, but they sound more like chirps and clucks.
Why do turkeys gobble back at you?
✓ Male turkeys/ toms gobble during the spring or fall. They do this during the mating season to attract the female hens. ... When a male is roosting and is trying to find out the location of the others, it gobbles and the other turkeys gobble in return. Hunters use this strategy to hunt wild turkeys all the time.
How far can a turkey gobble be heard?
As a general rule a gobble made in a tree can be heard twice as far as one made on the ground. That same “twice-as-far” rule applies to all other turkey sounds.
How often should you call for turkey?
Call every few minutes, and act like a disinterested hen going about her daily routine. Moving also helps in such situations, because turkeys rarely sit and yelp in one place for long.
Turkeys Gobbling - Funny Turkey Gobble Videos
25 related questions foundWhen should you start calling turkeys?
When To Call A Gobbler
In my view, the best times of the day are right off the roost, then again from about 8:30 to 9:30 when more hens start to leave the gobbler to go lay an egg, and again from about 11 until noon.
How far can a turkey see?
Turkeys also have true color vision, as well as 180-degree peripheral vision. With just a slight turn of their head, they can see 360 degrees. Therefore, their eyesight is a serious challenge for bowhunters to overcome. Turkey hunters must cover themselves in camouflage, including the face and hands.
Why do gobblers stop gobbling?
As a conservation measure the state purposely and prudently sets the start of the season to begin after the peak of gobbling, for the roughly two weeks before most hens start sitting on their nests. Toms naturally taper off in gobbling in this time, after the hide-and-seek of mating game has peaked, Duren said.
What time of day are turkeys most active?
General Weather Conditions: As a general rule of thumb, turkeys are most active during calm, clear days in morning and early afternoon hours. Turkey activity generally decreases with bad weather conditions including wind and rain.
What does it mean when a turkey gobbles?
The gobble is a loud, rapid gurgling sound made by male turkeys. The gobble is one of the principal vocalizations of the male wild turkey and is used primarily in the spring to let hens know he is in the area.
What sounds do male turkeys make?
Calls. Male turkeys are called “gobblers” because of their famous call, which is their version of a rooster's crow. It's a loud, shrill, descending, throaty jumble of sound that lasts about 1 second. Males often gobble from their treetop roosts, where the sound carries better than on the ground.
Why do turkeys gobble at night?
When they are sitting on the roost, gobblers tend to be more vocal since they are safe from predators and because they are trying to find the rest of the flock. Timing is everything. In the evenings wait to shock gobble turkeys until the last half hour of daylight.
Why do turkeys gobble some days and not others?
Some days, turkeys gobble from dawn to dark. Other days, they don't gobble at all. Why? The easy explanation is that they're unpredictable.
Do tom turkeys gobble?
Answer: Only male turkeys, or toms, can gobble, and they mostly do it in the spring and fall. It is a mating call and attracts the hens. Wild turkeys gobble at loud sounds and when they settle in for the night.
Where do turkeys hide during the day?
Although turkeys spend most of their time on the ground during the day, they sleep in trees at night. Turkeys cannot see well in the dark. Sleeping in trees provides protection from predators that roam and can see at night. They fly up to roost at dusk, and fly down at dawn to begin their daily rituals.
What do you do if you don't hear a gobble?
If you don't have a bird roosted and there are no gobbles at daybreak, consider heading straight to one of your good fields or strut zones immediately after first light. You want to make sure you beat the birds to the spot. Once there, set up and call softly for 10 minutes.
What time in the morning do turkeys start gobbling?
Beginning around 9:00 a.m. walk old logging roads, field edges, foot trails on ridges…you get the idea. Pause often and listen for gobbles. Try to strike toms with calls.
What to do when turkeys dont gobble?
Hunt in a high-percentage strut zone
Even if the birds aren't gobbling every time the wind blows, you can bet your biscuits & gravy they will still want to strut and drag those wings to impress all the single ladies and even the married ones! There are always areas that toms love to strut and be seen.
Do turkeys smell humans?
Sort of. For starters, turkeys have a very weak sense of taste. Like most birds, they only have a couple hundred taste buds, which is about 9000 less than a human. ... In a turkey, these are very small and underdeveloped, which leads scientists to believe that their sense of smell is almost nonexistent.
Can turkeys smell cigarette smoke?
Sad. Turkeys have a very poorly developed olfactory system. They can hardly smell anything.
Do turkeys have memory?
Turkeys have short term memory loss, and they also suffer from short term memory loss.
What time should you be in the woods for turkey hunting?
Most states allow hunting a half-hour before sunrise so be in the woods early. How early? Get to your setup site at least 30 to 45 minutes before shooting light.
How do you call in a gobbler?
Make a loud, short burst of crow or owl calls, and then listen for gobbles. If you get no response, walk 100 yards and repeat until hearing a gobble. Call again until pinpointing where they're roosted. When returning the next morning before dawn, set up within 200 yards of the roosting tree.
What time do turkeys fly up to roost?
This is not unique to turkeys; other game birds like the ruffed grouse also roost in trees during most of the year. Turkeys predictably fly up in a tree at dusk and come down in the morning to begin their day. This fact is a building block for successfully scouting and hunting turkeys.